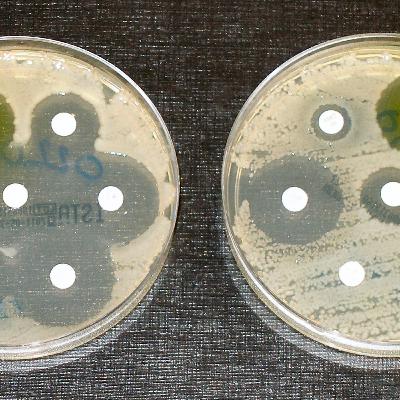
DrMcPharma ep. 29: Antibiotics: Golden Age to Resistance Crisis and Future Solutions

Discover
DrMcPharma
42Ā Episodes
Reverse
These resources provide a detailed overview of cutting-edge research intersecting T cell immunology, microbiome ecology, and antibiotic effects, often utilizing multi-omics approaches. A significant portion of the material focuses on T cell subsets crucial for immune regulation, specifically the roles of Regulatory T (Treg) cells in maintaining peripheral tolerance via mechanisms controlled by factors like the transcription factor FOXP3, and the differentiation and pathogenic activity of T helper 17 (Th17) cells implicated in autoimmune diseases, often regulated by cytokines (e.g., IL-21, TGF-β) and nuclear receptors (e.g., RORγt). Concurrently, numerous studies investigate the profound and often lasting impact of antibiotic exposure on the gut microbiome, detailing how antibiotics cause dysbiosis, reduce microbial diversity, select for resistance genes, and delay microbial maturation in early life, factors associated with increased susceptibility to conditions like allergic asthma and C. difficile infection (CDI). Mechanistically, these effects are linked to alterations in the metabolome, where microbial metabolites such as short-chain fatty acids (SCFAs) like butyrate and propionate are shown to causally relate to metabolic traits like insulin response and to actively promote the generation of anti-inflammatory Treg cells, while new diagnostic and therapeutic strategies are being developed, including narrow-spectrum antibiotics like lolamicin to spare the gut microbiome and advanced ingestible devices for localized intestinal profilingCollectively, these publications highlight the ongoing research into harnessing Treg biology for treating various diseases.
Keywordshand washing, public health, hygiene, Semmelweis, germ theory, soap, cleanliness, behavioral science, COVID-19, health practicesSummaryThis conversation explores the historical evolution of hand washing as a critical public health practice, tracing its roots from ancient cleanliness instincts to the tragic story of Ignaz Semmelweis, who proved the necessity of hand washing in medical settings. It discusses the scientific advancements by Pasteur and Koch that established germ theory, the role of soap in making hygiene accessible, and the mechanisms by which soap works to eliminate pathogens. Finally, it addresses the ongoing challenge of ensuring hand washing compliance in modern society, particularly in light of behavioral science insights.TakeawaysHand washing is a cornerstone of public health.Historically, hospitals were often places of death due to lack of hygiene.The concept of germs was unthinkable to early physicians.Cleanliness instincts are deeply rooted in human evolution.Religious practices historically promoted hygiene long before germ theory.Miasma theory led to positive public health actions despite being incorrect.Semmelweis's hand washing mandate drastically reduced maternal mortality rates.The scientific understanding of germs was developed by Pasteur and Koch.Soap became accessible due to industrial advancements and the repeal of taxes.Behavioral science is key to improving hand washing compliance.Chapters00:00 The Historical Context of Hand Washing02:46 The Evolution of Cleanliness and Hygiene Practices06:08 The Tragedy of Ignaz Semmelweis08:53 The Scientific Revolution: Pasteur and Koch12:13 The Role of Soap in Public Health14:58 The Mechanism of Soap and Hand Washing17:52 Behavioral Science and Hand Washing Compliance
Spotify LinkChapters00:00 The Paradox of Mental Health Investments03:09 Understanding Structural Determinants of Mental Health05:46 Economic Security and Mental Health09:03 The Built Environment's Impact on Well-Being11:57 Education as a Structural Asset15:13 Community and Social Fabric Interventions18:07 Addressing Macro-Level Challenges for Mental HealthKeywords: mental health, structural determinants, economic security, built environment, education, community, social fabric, policy interventions, climate change, digital divideSummary: This conversation explores the complex interplay between structural determinants and mental health, emphasizing the need for a paradigm shift in how we approach mental health interventions. It highlights the importance of economic security, the built environment, education, and community support in shaping mental well-being. The discussion also addresses macro-level challenges such as climate change and the digital divide, advocating for a comprehensive policy approach to create a more mentally healthy society.Takeaways: Despite massive investments, mental illness rates continue to rise. Mental health is influenced by macro-level factors like economics and social conditions. Chronic stress from structural inequities can lead to significant mental health issues. Discrimination has a profound negative impact on mental health. Economic security is crucial for improving mental health outcomes. Housing stability is foundational for mental well-being. School climate significantly affects student mental health. Community-led initiatives can effectively reduce stigma and improve mental health. Climate change is a critical structural determinant of mental health. Digital equity is essential for accessing mental health resources.
Spotify LinkThe source provides an extensive overview of theĀ significant transformation in breast cancer screening, detailing the shift from one-size-fits-all protocols to aĀ personalized, risk-stratified framework. It highlights the major 2024 guideline change by theĀ U.S. Preventive Services Task Force (USPSTF), which lowered the recommended starting age for biennial screening to 40, explicitly aiming to address theĀ persistent mortality gapĀ faced by Black women. The report emphasizes the current standard of care,Ā Digital Breast Tomosynthesis (3D mammography), which improves detection while reducing false positives, and discusses the ongoing tension between maximizing the life-saving benefits of early detection and minimizing harms like overdiagnosis. Furthermore, it explores the future of screening, focusing on the potential ofĀ Artificial Intelligence (AI)Ā for improved image interpretation and the development ofĀ liquid biopsiesĀ for earlier, molecular detection of cancer.
The source provides a comprehensive overview of theĀ pharmacological management of meningitis, detailing current international treatment protocols and emerging research strategies. It synthesizes guidelines from organizations like theĀ WHO, IDSA, and ESCMID, establishing a global consensus on the urgent use of empiric antibiotics, primarily third-generation cephalosporins, and the critical, pathogen-specific role ofĀ adjunctive dexamethasone. The text highlights the major threat ofĀ antimicrobial resistance (AMR)Ā in organisms likeĀ S. pneumoniaeĀ andĀ N. meningitidis, which necessitates tailored therapy and strong stewardship programs. Furthermore, the report explores theĀ research frontier, including novel, shorter regimens for tuberculous meningitis, new oral antifungals for cryptococcal disease, and advances inĀ nanotechnology and drug deliveryĀ designed to overcome the blood-brain barrier.
The source provides a comprehensive overview of theĀ evolution and current state of health literacyĀ in the United States, emphasizing a paradigm shift from focusing solely on individual capacity to incorporatingĀ systemic and organizational responsibility. It explains how the Healthy People 2030 initiative formally introduced the dual concepts ofĀ personal health literacyĀ andĀ organizational health literacyĀ to promote equity. The text details theĀ pervasive negative impact of limited health literacyĀ on clinical outcomes and the staggering economic burden it places on the healthcare system. Furthermore, it outlines theĀ federal and organizational response, including the National Action Plan and the Ten Attributes of a Health-Literate Organization, while exploring keyĀ evidence-based interventionsĀ such as Plain Language and the Teach-Back method. Finally, the source addresses the growing importance ofĀ digital health literacyĀ and the need for new research to evaluate the cost-effectiveness and scalability of interventions.
Rabies Lyssavirus: Virology, Pathogenesis, and Genomic EpidemiologyThe source provides an extensive overview ofĀ Rabies lyssavirus (RABV), covering its molecular architecture, pathogenesis, and modern epidemiological tracking. It first describes the virus's taxonomy within theĀ LyssavirusĀ genus, detailing the clinically criticalĀ Phylogroup IĀ and the bullet-shaped structure of the virion, emphasizing the role of theĀ Glycoprotein (G)Ā in infectivity and theĀ Nucleoprotein (N)Ā andĀ Phosphoprotein (P)Ā in forming dynamic viral factories called Negri bodies. The text then addresses pathogenesis, explaining how the virus achieves neuroinvasion by hijacking host axonal transport and its sophisticated strategies for evading theĀ interferon (IFN) system, primarily through the P protein. Finally, the source highlights the transformational impact ofĀ genomic epidemiologyĀ andĀ Next-Generation Sequencing (NGS), illustrating how this technology is used to reconstruct global transmission pathways, analyze the role of reservoir hosts, and inform strategies for achieving the global goal of rabies elimination by 2030.
The source provides a comprehensive overview of the paradigm shift occurring in Alzheimer's disease (AD) therapeutics, detailing the move fromĀ modest symptomatic reliefĀ to the firstĀ disease-modifying therapies (DMTs). It explains that while traditional treatments like cholinesterase inhibitors temporarily managed symptoms, recent FDA approvals of anti-amyloid antibodies, such asĀ lecanemab and donanemab, prove that targeting underlying pathology can slow cognitive decline, despite introducing safety risks like ARIA. The text further highlights theĀ diversifying drug pipelineĀ beyond amyloid to include anti-tau agents, neuroinflammation modulators, and repurposed drugs like semaglutide. This progress is underscored by aĀ revolution in diagnostics, where non-invasive blood-based biomarkers like p-tau217 now enable earlier and more accurate patient identification, supporting a future model ofĀ integrated, personalized AD careĀ that combines pharmacotherapy with lifestyle interventions like those validated by the U.S. POINTER trial.
This source provides a comprehensive review of the evidence regardingĀ folic acid supplementationĀ for preventing neurodevelopmental defects, emphasizing its established role in preventingĀ neural tube defects (NTDs), which has led to a global consensus for daily intake of 400ā800 µg for all women of childbearing age. Beyond NTDs, the text examines the expanding research linking adequate maternal folic acid toĀ improved cognitive outcomesĀ and a reduced risk of disorders likeĀ Autism Spectrum Disorder (ASD)Ā andĀ Attention-Deficit/Hyperactivity Disorder (ADHD). However, it introduces the complexity of a potentialĀ U-shaped risk curve, noting that both deficiency and excessive intake may be detrimental and that the efficacy and safety of folic acid are critically dependent on its metabolic partner,Ā Vitamin B12, highlighting the need for a balanced "metabolic optimization" approach. Finally, the source discusses the ongoing debate between syntheticĀ folic acidĀ and the active form,Ā L-methylfolate, particularly for individuals with MTHFR gene variations.
Keywords: U.S. healthcare system, healthcare costs, insurance coverage, healthcare access, healthcare quality, healthcare reform, Affordable Care Act, Medicare, Medicaid, healthcare paradoxSummary: This conversation delves into the complexities of the U.S. healthcare system, exploring its paradox of high spending yet poor health outcomes. It discusses the intricate financing structure, the role of insurance, and the challenges of cost, access, and quality. The dialogue also touches on the Affordable Care Act and the ongoing debates surrounding healthcare reform, highlighting the need for a comprehensive understanding of the system's intricacies.Takeaways: The U.S. spends more on healthcare than any other developed nation.Despite high spending, U.S. health outcomes lag peer nations.The healthcare system is a complex mix of private and public financing.Cost-sharing mechanisms often create barriers to necessary care.The U.S. has a tiered healthcare system based on employment and income.The Affordable Care Act significantly reduced the uninsured rate.Medicare and Medicaid play crucial roles in the healthcare landscape.Healthcare access is affected by both financial and non-financial barriers.There are significant health disparities across racial and socioeconomic lines.Future healthcare reform is likely to be a contentious political issue.
The source outlines the significant challenges within theĀ U.S. healthcare system, including its high costs, fragmented access, inconsistent quality, and substantial administrative burden. It contrasts this with theĀ Japanese healthcare model, which achieves universal coverage, cost control, and superior health outcomes through aĀ regulated multi-payer social insurance systemĀ and aĀ national, uniform fee schedule. The text then proposes a comprehensiveĀ four-pillar blueprintĀ forĀ U.S. reform, advocating forĀ universal, mandatory coverage,Ā national fee regulation,Ā radical administrative simplification, and a reorientation ofĀ care delivery towards stronger primary careĀ based on principles adapted from the Japanese system. Finally, it discusses theĀ political, economic, and social considerationsĀ crucial for implementing such a transformative reform in the United States.
The provided resource collectively examines the multifaceted impacts of climate change on the United States, with a particular focus on itsĀ economic and societal consequences. TheĀ Congressional Budget OfficeĀ report offers a comprehensive analysis of how rising temperatures and natural disasters could affect the nation'sĀ Gross Domestic Product (GDP),Ā real estate markets, and various other aspects likeĀ human health,Ā biodiversity,Ā immigration, andĀ national security, highlighting uncertainties and potential tipping points. Complementing this, theĀ U.S. Department of the TreasuryĀ details the direct financial strain climate hazards place onĀ American households, including reduced income, property damage, and increased costs for essentials like transportation, healthcare, and utilities, while also proposingĀ mitigation strategiesĀ for both consumers and policymakers. Finally, theĀ National Oceanic and Atmospheric AdministrationĀ reinforces these concerns, asserting that climate change impacts are escalating for Americans, withĀ significant financial repercussionsĀ and disproportionate effects onĀ underserved communities. TheĀ EPIC (Energy Policy Institute at the University of Chicago)Ā source broadly indicates a research focus on the global energy challenge, climate change impacts, and related policy solutions.https://www.nature.com/articles/d41586-025-02505-xhttps://epic.uchicago.edu/area-of-focus/climate-change-and-the-us-economic-future/https://www.noaa.gov/news-release/climate-change-impacts-are-increasing-for-americanshttps://www.cbo.gov/publication/61146https://www.nber.org/papers/w32450https://home.treasury.gov/news/press-releases/jy1775
Here we provide a comprehensive overview of Alzheimer's disease (AD) research, tracing its evolution from its initial discovery to current and future directions. This resource explains how AD wasĀ historically misunderstood as a rare conditionĀ before being redefined as a major public health crisis, leading to theĀ development of the amyloid cascade hypothesisĀ as a dominant theory. This resources details theĀ challenges and failures of early anti-amyloid drug trials, which ultimately broadened scientific understanding beyond a single-target approach. Crucially, the resource highlightsĀ recent breakthroughs in disease-modifying therapiesĀ like lecanemab and donanemab, alongside aĀ revolution in diagnosticsĀ through advanced imaging and blood tests. Finally, it explores theĀ future of AD research, focusing on prevention, combination therapies, and precision medicine, acknowledging the disease's multifaceted nature.
Bacterial Antimicrobial Resistance: Antibiotic ResistanceThe provided text outlines theĀ history of antibiotics, beginning with the serendipitous discovery and subsequent industrialization ofĀ penicillin, which marked the dawn of the antibiotic era. It then details theĀ "Golden Age" of antibiotic discoveryĀ (1944-1970), a period of unprecedented output due to systematic screening methods. However, the document highlights theĀ inevitable emergence of antimicrobial resistance (AMR), explaining its biological mechanisms and the human activities, such as overuse in medicine and agriculture, that have accelerated its spread. Finally, the text addresses theĀ current dual crisis of AMR: a dwindling pipeline of new antibiotics due to significant scientific and economic hurdles, and the escalatingĀ human and economic costsĀ of untreatable infections. The conclusion emphasizes the urgent need for aĀ multi-pronged global strategyĀ involving new scientific approaches and innovative economic policies to combat this growing public health threat.
Like, Follow, Bookmark, Share, Subscribe to our: Spotify: https://open.spotify.com/show/1MjuzLOKI5hplPrhkxR1SK Site: ā ā https://drmcpharma.comSocials: ā ā ā https://linktr.ee/drmcpharma& Others: https://creators.spotify.com/pod/profile/drmcpharma/The Human Genome Project [NIH NHGRI] was a monumental international scientific undertaking launched in 1990 and completed in 2003. We detail the project'sĀ origins and scientific precursors, highlighting key discoveries like DNA's double helix and the development of sequencing methods that made the HGP feasible. This source explains theĀ global collaborative effortĀ that defined the HGP, including the establishment of theĀ Bermuda Principles for open data sharing, and contrasts the public project'sĀ hierarchical sequencing strategyĀ with the faster, privately fundedĀ Celera Genomics' whole-genome shotgun approach, detailing their fierce rivalry and eventual joint announcement of a draft sequence. Finally, we explore theĀ HGP's surprising scientific findings, such as the relatively low number of human genes and the revelation about "non-coding DNA," and discusses the project'sĀ lasting legacyĀ in transforming medicine through precision approaches and advancing our understanding of human evolution, while also emphasising the pioneeringĀ Ethical, Legal, and Social Implications (ELSI) programme.
Investment in biomedical scienceĀ in the United States, particularly through federal funding via theĀ National Institutes of Health (NIH), offers significant advantages for bothĀ public health and the economy. This fundingĀ generates substantial economic activityĀ andĀ supports numerous jobsĀ across the nation, while also leading toĀ improved health outcomes,Ā increased life expectancy, and aĀ reduction in disease burdenĀ through breakthroughs in prevention, diagnosis, and treatment. TheĀ methods used to quantify these returns, such as economic impact modelling and health metrics likeĀ Quality-Adjusted Life Years (QALYs), acknowledges theĀ inherent challenges in measuringĀ such complex and long-term impacts, including difficulties inĀ attribution and data collection, alongsideĀ ethical considerationsĀ in valuation. Ultimately, the sustained investment into biomedical science isĀ crucial for national well-beingĀ andĀ economic competitiveness.
Vaccination stands as one of humanity's most significant public health achievement, fundamentally altering the landscape of infectious diseases and preventing millions of deaths globally. This report delves into the specific journeys of five critical vaccines: influenza, Respiratory Syncytial Virus (RSV), SARS-CoV-2, varicella, and measles. Each represents a unique narrative of scientific discovery, persistent challenges, and remarkable breakthroughs that continue to shape our approach to global health security.The diseases covered herein range from long-standing endemic threats like measles and influenza to more recently recognized, yet highly impactful, pathogens such as RSV and SARS-CoV-2. Understanding their vaccine histories provides crucial context for appreciating current advancements and anticipating future directions in preventive medicine. The continuous evolution of vaccine science underscores its vital role in safeguarding population health against both established and emerging infectious threats.
This scientific text explores theĀ molecular pharmacology of caffeineĀ in the human body, detailing how this widely consumed substance impacts physiological and neurological functions. It explains caffeine'sĀ absorption and metabolism, highlighting the role of the CYP1A2 enzyme and the formation of active metabolites like paraxanthine, theobromine, and theophylline, while also discussingĀ individual metabolic variability. The primary mechanism of caffeine,Ā adenosine receptor antagonism, is thoroughly described, including its structural mimicry of adenosine and subsequent effects on neurotransmitters like dopamine and norepinephrine. Finally, the document examinesĀ secondary molecular mechanismsĀ that occur at higher caffeine concentrations, such as phosphodiesterase inhibition and intracellular calcium mobilization, alongside theĀ molecular adaptationsĀ the body undergoes with chronic caffeine consumption, leading to tolerance and withdrawal.
1. Office of Disease Prevention and Health Promotion MyHealthFinder2. CDC Vaccines3. World in Data: Vaccines
Podcasts: ā https://creators.spotify.com/pod/profile/drmcpharma/ā Socials: ā ā https://linktr.ee/drmcpharmaWebsite: https://drmcpharma.comThe global health landscape is undergoing a profound transformation, driven by the escalating impacts of climate change, global warming, and the increasing frequency and intensity of extreme weather events. Far from being a distant environmental concern, climate change has emerged as an immediate and rapidly worsening public health emergency, with measurable and devastating consequences for human health and well-being worldwide. Authoritative reports from leading international bodies, including the World Health Organization (WHO), the Intergovernmental Panel on Climate Change (IPCC), the Lancet Countdown on Health and Climate Change, and the World Bank, present a converging scientific consensus: the crisis is accelerating, its impacts are more widespread and severe than anticipated, and vulnerable populations bear a disproportionate burden.Direct health consequences are manifesting through rising heat-related morbidity and mortality, a surge in injuries and fatalities from extreme weather events, and profound psychological distress. Simultaneously, climate-driven environmental shifts are altering the epidemiology of infectious diseases, exacerbating respiratory conditions, and deepening global food insecurity. The economic toll of these health impacts is staggering, with projections indicating billions in annual costs and millions pushed into extreme poverty.Despite the mounting evidence, significant gaps persist in quantitative research on health adaptation effectiveness, and a critical disconnect remains between scientific understanding and the integration of health into national climate policies. This report synthesizes the latest research, highlighting the multifaceted health threats, the complex mechanisms at play, and the urgent need for integrated global action. It underscores that climate action is fundamentally a public health intervention, offering substantial co-benefits and presenting an ethical and practical imperative for immediate, coordinated, and equitable responses across all sectors.